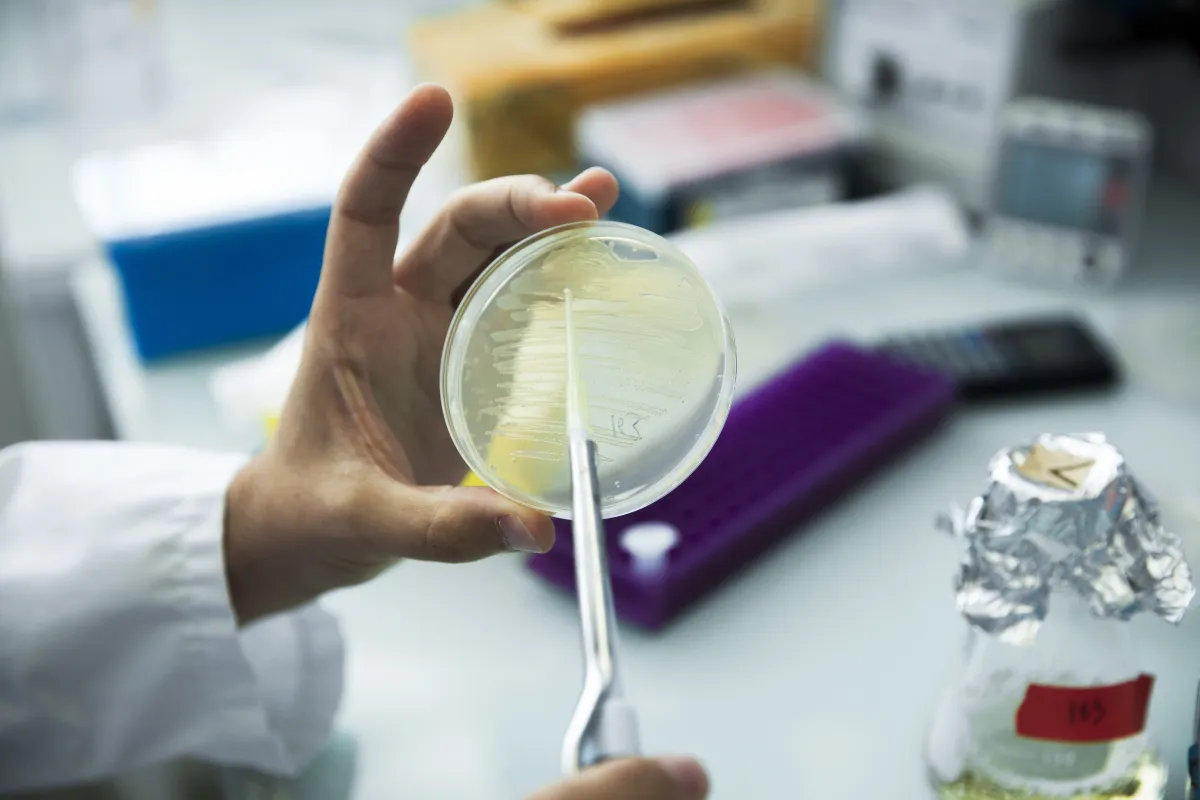

Bernard De Massy Comprendre le contrôle du couper-coller chromosomique
Bernard de Massy, docteur en biologie rattaché à l'Institut de génétique humaine de Montpellier
- 2016 • Prix Bettencourt Coups d’élan pour la recherche française



Le Prix Bettencourt Coups d’élan pour la recherche française 2016 récompense Benard de Massy, Docteur en biologie, pour ses recherches sur les cassures chromosomiques.
Un échange d'allèles à haut risque
L'équipe de Bernard de Massy identifie chez la souris les mécanismes moléculaires par lesquels les chromosomes échangent du matériel génétique dans les cellules destinées à devenir ovocytes et spermatozoïdes. La reproduction sexuée a pour rôle de mélanger pour innover, tout en protégeant ce qui ne doit pas être altéré. Les gamètes mâles et femelles sont formés à l'aide d'une division spécifique, la méiose, qui, avant de séparer le génome en deux, opère à la recombinaison entre chromosomes homologues. Cet échange d'allèles n'est pas sans risque, puisque pour construire les enjambements qui lieront les chromosomes lors de l’échange, l'organisme impose à l'ADN des futurs gamètes, des cassures double-brins. Ces coupures de la double-hélice peuvent avoir des conséquences désastreuses pour la cellule, l'organisme et sa descendance (les maladies génétiques ou la stérilité). Le processus est donc strictement contrôlé.
Mieux comprendre les cassures double brins
L'équipe de Bernard de Massy enquête sur les mécanismes moléculaires qui encadrent le timing, le nombre, la localisation et la réparation des cassures double brins. Ces éléments sont cruciaux pour la bonne répartition des chromosomes entre les cellules filles. L'équipe a notamment identifié trois protéines, PRDM9, SPO11 et, très récemment, TopoVIB-L, qui interagissent avec d'autres facteurs pour provoquer la cassure double-brin à des endroits spécifiques de la molécule d'ADN.
Le soutien de la Fondation
Dans le projet soutenu par la Fondation, les chercheurs vont s'appuyer sur des recherches in vivo et in vitro pour raffiner un modèle montrant comment ces facteurs agissent, coopèrent et sont régulés pour promouvoir la recombinaison méiotique. Le prix Coup d'élan va permettre à l'équipe de mettre en place des approches génomiques, très gourmandes en capacité de stockage et traitement informatique, pour répondre à ces questions fondamentales. La nouvelle infrastructure informatique sera également mise à disposition de l’Institut de Génétique Humaine à Montpellier.
Bernard de Massy en quelques mots
Ingénieur agronome de formation, Bernard de Massy transforme son intérêt pour la transmission héréditaire de l’information génétique en une thèse de doctorat sur la réplication de l’ADN de la bactérie Escherichia coli. Recruté au CNRS, il se forme peu à peu au travail avec la souris, modèle idéal pour étudier les mécanismes basiques de ségrégation des chromosomes durant la méiose et mieux comprendre la contribution de la recombinaison dans l'évolution du génome. Il fait chez le rongeur plusieurs découvertes importantes, dont Spo11, enzyme qui catalyse la formation des cassures double-brin dans l'ADN méiotique. Près de vingt ans plus tard, son équipe trouve enfin la protéine partenaire la plus proche de Spo11 : TopoVI-BL. Avec la découverte de nombreux autres facteurs, dont PRDM9, qui cible Spo11 sur différents endroits du génome et offre une dynamique inattendue au processus de recombinaison, les travaux de Bernard de Massy dévoilent progressivement un mécanisme raffiné susceptible d'opérer des changements rapides dans l'architecture des génomes.

Prix Bettencourt Coups d’élan pour la recherche française
Le Prix Coups d’élan pour la recherche française a été créé par la Fondation en 2000, il a récompensé 78 laboratoires français et plus de 900 chercheurs ont bénéficié de ce prix. Jusqu'en 2021, ce prix était attribué chaque année à quatre équipes de recherche, relevant de l’Inserm et de l’Institut des sciences biologiques du CNRS. La dotation du prix était de 250 000 euros par laboratoire lauréat.
Tous les lauréats du prix